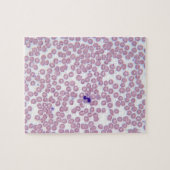
Malariablutzellen Puzzle (Horizontal)

Über Puzzles
Verkauft von
Über dieses Design
Malariablutzellen Puzzle
Malariische Blutzellen | "Michael J. Klein, M.D." | AssetID: 142021985
Automatische Übersetzung
Kundenrezensionen
5.0 von 5 Sternen Bewertung9 Bewertungen insgesamt
9 Bewertungen
Bewertungen für ähnliche Produkte
5 von 5 Sternen Bewertung
Von Heiko S.10. Mai 2022 • Geprüfter Kauf
Puzzle, 20,3 cm x 25,4 cm, 110 Teile
Bewertungsprogramm bei Zazzle
Schönes Puzzle und gute Qualität. Hochwertiger Druck. Immer wieder gerne
5 von 5 Sternen Bewertung
Von J.19. Dezember 2021 • Geprüfter Kauf
Puzzle, 40,6 cm x 50,8 cm, 520 Teile
Bewertungsprogramm bei Zazzle
Sehr schönes Bild wunderbare Farben. Farben sind wie auf dem Bild
5 von 5 Sternen Bewertung
Von Monika S.26. Januar 2022 • Geprüfter Kauf
Puzzle, 20,3 cm x 25,4 cm, 110 Teile
Bewertungsprogramm bei Zazzle
Super.Ich freue mich darauf es fertig zu sehen. Super,alles Super,für schöne Stunden
Tags
Andere Informationen
Produkt ID: 116689754979453795
Gemacht am: 29.10.2012, 15:43
Bewertung: G
Zuletzt angesehene Produkte